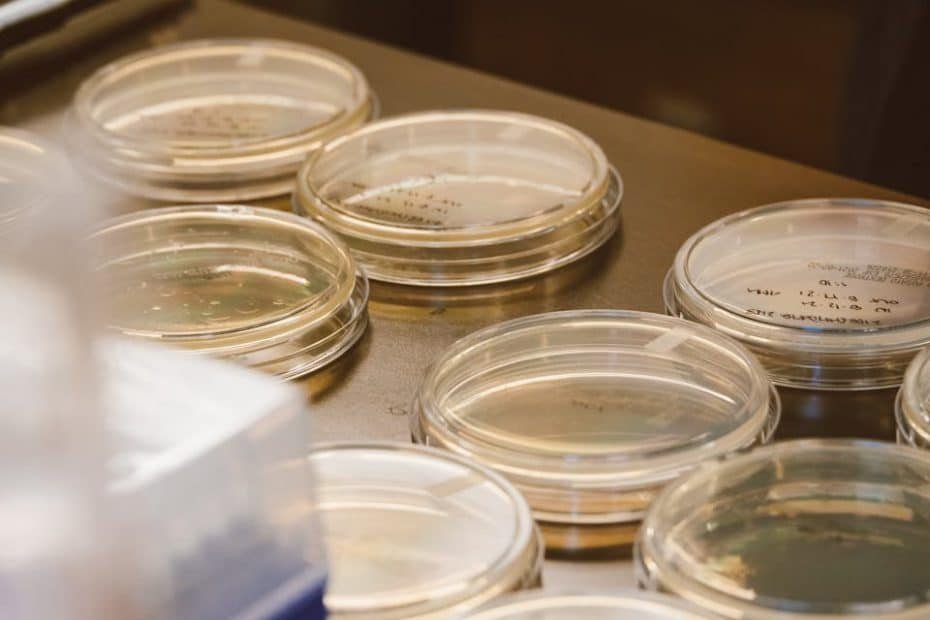
Close-up of glass Petri dishes in a laboratory, ideal for science and microbiology themes.

Was ist Agar?
Agar ist eine transparente, geruchlose und geschmacklose gelatinöse Substanz, die aus Rotalgen gewonnen wird.
Es wird als Geliermittel, Verdickungsmittel und Stabilisator in Lebensmitteln verwendet und um nährstoffreiche Wachstumsmedien für Pilzsporen und Myzel zu schaffen.
Wie funktioniert Agar?
Agar ist bei Raumtemperatur fest. Wie Gelatine wird es als Festigungsmittel verwendet. Je mehr Agar du einer Mischung hinzufügst, desto fester wird das endgültige Wachstumsmedium.
Agar für Pilze vorbereiten
Um Agar für die Pilzzucht vorzubereiten, kombinierst du es mit einer nährstoffreichen Substanz und Wasser und sterilisierst dann die entstehende Mischung in einem Schnellkochtopf oder Autoklav.
Warum Agar-Platten verwenden?
Agar-Platten sind Petrischalen, die eine sterile, nährstoffreiche Agar-Lösung enthalten, welche Nährstoffe für das Myzelwachstum in der sterilen Umgebung innerhalb der Petrischalen bereitstellt.
Die Hauptvorteile von Agar-Platten:
- Klonen von Pilzen: Ermöglicht das Klonen von Pilzen und die Keimung neuer Stämme aus Pilzsporenabdrücken mit geringerem Kontaminationsrisiko
- Kontaminationserkennung: Agar ist farblos, wodurch es einfach ist, Pilzkontaminationen zu erkennen und zu entfernen
- Myzel-Rettung: Bei Kontamination kannst du ein Stück gesundes Myzel ausschneiden und auf eine andere sterile Platte übertragen
- Langzeitspeicherung: Ermöglicht die Aufbewahrung von Pilzmyzel über lange Zeiträume
💡 Tipp zur Langzeitaufbewahrung: Sobald eine Petrischale vollständig kolonisiert ist, kannst du sie in einem versiegelten Plastikbeutel im Kühlschrank aufbewahren, und das Myzel kann bis zu 12 Monate lebensfähig bleiben.
Agar-Platten Schritt für Schritt herstellen
Dieser Artikel konzentriert sich auf die Herstellung von hellem Malzextrakt-Agar-Platten, die die meisten Speisepilzarten unterstützen.
Du benötigst dieselbe Ausrüstung für andere Rezepte. Der einzige Unterschied liegt darin, was du als Nährstoffquelle für das Pilzmyzel verwendest.
Schritt 1: Material sammeln
Der erste Schritt ist, alle Materialien und Geräte zu sammeln, die du für die Herstellung von Agar-Platten benötigst:
Grundzutaten:
- Agar-Agar – Nicht immer lokal verfügbar, möglicherweise online bestellen
- Heller Malzextrakt – In Brauereigeschäften oder online erhältlich
- Nährhefe (optional) – In Bioläden und Bio-Supermärkten
- Wasser – Destilliertes Wasser wird empfohlen, Leitungswasser geht auch
Ausrüstung:
- Petrischalen – Online von Laborbedarf-Unternehmen bestellen
- Weithalsgläser – Einmachgläser mit gelochten Deckeln funktionieren gut
- Polyfill-Füllmaterial – Als Filter in den Deckellöchern verwenden
- Alufolie – Zum Abdecken der Deckel während der Sterilisation
- Digitalwaage – Für genaue Messung der trockenen Zutaten
- Schnellkochtopf – Für die Sterilisation
- Sauberer Arbeitsplatz – Still-Air-Box oder Laminar-Flow-Hood
Schritt 2: Zutaten mischen
Genaue Messungen sind entscheidend bei der Herstellung von Agar-Platten, da falsche Mengen zu langsamerem Myzelwachstum führen und die Kontaminationsgefahr erhöhen können.
⚠️ Wichtiger Tipp: Verwende deine Digitalwaage, um 10g Agar und 10g hellen Malzextrakt zu messen, und einen Glasmessbecher für das heiße Wasser.
Viele Züchter verwenden kochendes Wasser, aber heißes Leitungswasser funktioniert auch. Denke daran: Agar, das zu kaltem Wasser hinzugefügt wird, beginnt sofort zu erstarren, was das Mischen erschwert.
Gib die trockenen Zutaten zum heißen Wasser in deinen Messbecher und rühre kräftig um, bis Agar und Malzextrakt aufgelöst sind.
Schritt 3: Sterilisieren
Deine Lösung ist bereit für die Sterilisation, sobald die trockenen Zutaten vollständig aufgelöst sind.
Gieße die Lösung in deine Gläser oder Flaschen und fülle sie etwa zu zwei Dritteln, um zu verhindern, dass sie während der Sterilisation überkochen.
Sterilisationsprotokoll:
- Gläser mit modifizierten, polyfill-gefüllten Deckeln verschließen
- Deckel mit Alufolie abdecken
- Gläser aufrecht auf einem Rost in den Schnellkochtopf stellen
- 30 Minuten bei 15 PSI sterilisieren
- Auf 46-52°C abkühlen lassen (2-3 Stunden)
⚠️ Achtung: Die Zeitnahme beginnt erst, wenn der Schnellkochtopf 15 PSI erreicht hat. Das Gießen der Platten bei zu heißer Mischung kann Plastik-Petrischalen verformen oder beschädigen.
Schritt 4: Agar gießen
Einer der wichtigsten Faktoren für den Erfolg in dieser Phase ist die Arbeit in einer sauberen, sterilen Umgebung zur Kontaminationsvermeidung.
🔬 Sterile Arbeitsumgebung: Idealerweise solltest du vor einer Laminar-Flow-Hood arbeiten, aber eine Still-Air-Box hilft auch dabei, Kontaminationen zu reduzieren.
Gießtechnik:
- Erste Petrischale öffnen
- Etwas Agar-Mischung eingießen (genug, um den Boden zu bedecken)
- Schnell schließen und zur nächsten Schale wechseln
- Alle Petrischalen nacheinander in einer Session gießen
- Das Innere der Schale nicht mit den Händen berühren
- Deckel jeder Petrischale so kurz wie möglich offen lassen
Lasse die Petrischalen vor deiner laufenden Laminar-Flow-Hood oder in der Still-Air-Box gestapelt, bis sie auf Raumtemperatur abgekühlt sind.
Schritt 5: Agar-Platten versiegeln
Du musst etwa 30 Minuten bis 1 Stunde warten, bis die Agar-Platten abgekühlt und erstarrt sind.
💧 Kondensation: Während des Abkühlens können einige Platten Kondensation auf der Innenseite der Deckel bekommen. Diese anfängliche Kondensation verschwindet normalerweise und ist meist kein Problem.
Falls du nicht alle Agar-Platten sofort verwenden möchtest, musst du sie für die Lagerung versiegeln.
Versiegelung mit Parafilm:
- Schneide ein Stück Laborparafilm von etwa 7-10 cm Länge ab
- Ziehe das Papier ab
- Falte den 5 cm breiten Parafilm der Länge nach in der Mitte
- Wickle den Parafilm um den Rand der Petrischale
- Dehne ihn, bis er an der Schale haftet
🔧 Warum Parafilm? Die meisten Züchter sind sich einig, dass Labor-Parafilm das beste Material zum Versiegeln von Agar-Platten ist, weil es atmungsaktiv, flexibel ist und Kontaminationen verhindert.
Schritt 6: Agar-Platten lagern
Optimale Lagerungsbedingungen:
- Temperatur: 2-4°C im Kühlschrank
- Aufbewahrung: In versiegeltem Behälter oder Plastikbeutel
- Haltbarkeit: 2-4 Wochen für beste Ergebnisse
Vor der Verwendung:
- Platten sorgfältig auf Kontaminationszeichen prüfen
- Auf Raumtemperatur erwärmen lassen vor dem Öffnen
- Dies hilft, Kondensation zu verhindern, die Kontaminationen verursachen kann
Zusammenfassung
Agar-Platten ermöglichen es dir, Pilze zu klonen, neue Stämme aus Sporenabdrücken zu keimen und Pilzmyzel mit geringerem Kontaminationsrisiko zu lagern.
Wenn du gerne experimentierst und den gesamten Pilzanbau-Prozess erleben möchtest, werden Agar-Platten dein Leben einfacher machen.
Aber wenn du mehr daran interessiert bist, Pilze gewinnbringend anzubauen oder eine kleine Pilzfarm zu gründen, empfehlen wir, den Agar-Teil zu überspringen und Getreide-Substrat zu kaufen, um dein Pilz-Substrat zu beimpfen.
Weitere Ressourcen
Um mehr über den Low-Tech-Anbau von Pilzen zu erfahren, besuche spezialisierte Pilzanbau-Hubs oder probiere Pilzzucht-Kurse aus.